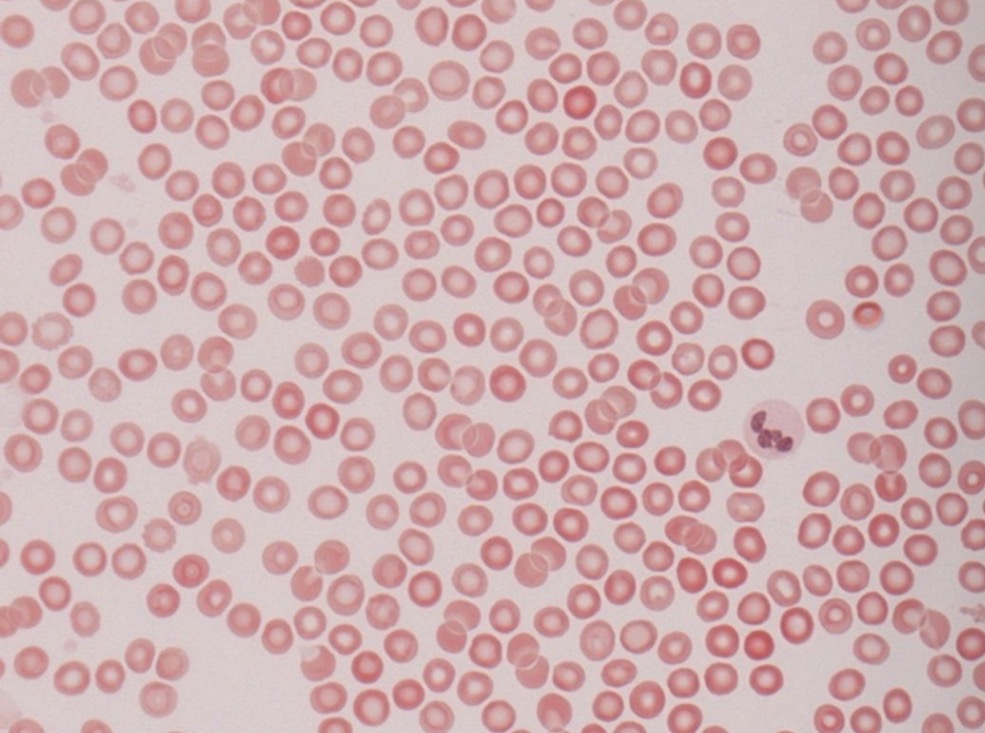
<ul><li><p>eritrocitai</p></li><li><p>Leikocitai</p></li><li><p>Kraujo ploksteles nera lasteles, ju vadinti trombocitais negalim, jos yra citoplazmos atplaisos</p></li></ul><p></p>

1/73
Looks like no tags are added yet.
Name | Mastery | Learn | Test | Matching | Spaced | Call with Kai |
|---|
No analytics yet
Send a link to your students to track their progress
Kaip klasifikuojami jungiamieji audiniai?
GEMALO : mezenchima drebutinis
SUAUGUSIOJO: skaidulinis ir specialusis
skaidulinis i kolagenini (purusis ir glaudusis (taisyklingasis, netaisyklingasis)) ir elastini
Slecialusis i krauja ir limfa, riebalinis, pigmentinis, tinklinis (retikulinis), griauciu

Kas sudaro jungiamaji audini?
Tarplasteline medziaga + lasteles
Kas sudaro tarplasteline medz?
Pagr medziaga + skaidulos
Kokios yra jungiamojo audinio lasteles?
Savosios
Atkeliavusios
Kas sudaro jungiamojo audinio tarplastelines medziagos pagrindine medziaga?
intersticinio skysčio
trijų rūšių makromolekulių:
1. Glikozaminoglikanų (GAGs)
2. Proteoglikanų
3. Glikoproteinu
Kas yra glikozaminglikanai?
ilgos disacharidų grandinės
• Didžiausias – hialuronas, kurį ląstelės sintetina tiesiai į tarpląstelinę terpę
• Kiti glikozaminoglikanai mažesni, susijungę su proteoglikanais, sintetinami Goldžio komplekse (pvz. dermatinsulfatas, chondroitinsulfatai, heparinsulfatai ir t.t.
Kas yra proteoglikanai?
aminorūgščių grandinės, sintetinamos ląstelės šiurkščiajame ET, Goldžio komplekse prie jų prijungiamos GAGs grandinės
Kokia yra glikoproteinu funkcija?
Sutvirtina audinį, stabilizuoja ląsteles ( nes turi sritis skirtas prisijunti kitoms molekulems) ir padeda jų migracijai
Pvz glikoproteinu
lamininas (gausu epitelio pamatinėje membranoje),
fibronektinas (sintetina fibroblastai),
osteopontinas
Kokios yra jungiamojo audinio tarplastelines medziagos skaidulos?
Kolageno
Tinklines
Elastines
I ka skirstomos kolageno skaidulos pagal struktura?
1. Fibriliniai kolagenai sudaro šviesiniu mikroskopu matomas kolageno skaidulas (I, II ir III tipo kolagenas)
2. Tinkliniai/plokšteles formuojantys (pvz. IV tipo kolagenas)
3. Jungiantys kolagenai sujungia fibrilinius kolagenus į skaidulas ir pluoštus (pvz. VII tipo kolagenas)
~90% visų žmogaus kūne randamų skaidulų sudaro ….. tipo kolageno skaidulos
1, 2 arba 3
Kur randamos I, II, III tipo skaidulos?
I tipo - Skaiduliniai JA, Kaulinis audinys, Skaidulinė kremzlė, Pigmentinis JA
II tipo - kremzles, stiklakunis
III tipo - skaiduliniai JA, liaukos, imuniniai organai, kaulu ciulpai
Kas sintetina kolageno skaidulas? Kur sintetina?
Fibroblastocitai, Sintezė vyksta ląstelėje,
tačiau skaidulos susiformuoja tarpląstelinėje terpėje
Kas sudaro tinklines skaidulas?
III tipo kolagenas
Kas sintetina tinklines skaidulas?
Tinklines lasteles - retikulocitai
Fibroblastai
Kur randamos tinklines skaidulos?
Daugelyje organu, ypac imuniniuose ir kraujodaros
Is ko sudarytos elastines skaidulos?
Baltymo elastino
Baltymo fibrilino
Kas sintetina elastines skaidulas?
Fibroblastocitai
Kokia yra elastiniu skaidulu savybe?
Turi elastingumo, gali sudaryti elastines membranas (arterijos)
Kur randamos elastines skaidulos?
Randamos daugelyje organų kartu su kolageninėmis skaidulomis (ypač organuose, kurie keičia tūrį, pvz. plaučiai)
Kokios lasteles yra savosios?
1. Fibroblastocitai
2. Fibrocitai
3. Retikulocitai (tinklinės
ląstelės)
4. Pericitai
5. Putliosios ląstelės
6. Adipocitai
7. Pigmentinės ląstelės
(melanocitai)
Kokios lasteles yra atkeliavusios?
1. Granulocitai
2. Limfocitai → Plazmocitai
3. Monocitai → Makrofagocitai
Fibroblastocitu savybes
• Aktyviai sintetina tarpląstelinės medžiagos komponentus
• Jautrūs augimo faktoriams
• Branduolys ovalus, euchromatiškas, matomas branduolėlis, gerai išvystytas šiurkštusis ET ir Goldžio aparatas

Fibrocitu savybes
• Neaktyvi ląstelė (sintezės aspektu)
• Branduolys heterochromatiškas, verpstės formos
• Gali virsti aktyvia (ypač įvykus audinio pažeidimui)

Retikulocitu funkcija
sintetina III tipo kolageną
Kur randami retikulocitai?
Tinkliniame jungiamajame audinyje, Savo citoplazmos ataugomis ląstelės iš dalies pridengia kolageno skaidulas, taip sudarydamos tinkla

Kokia yra putliuju lasteliu funkcija?
Sintetina daug bioaktyvių medžiagų, reikalingų audinių imuniniam atsakui, uždegimui ir gijimui inicijuoti
Kaip issidesto putliosios lasteles?
Dažniausiai dėstosi prie kraujagyslių, kvėpavimo takų epitelio pamatinės membranos

Ko turi putliosios lasteles citoplazmoje?
Bazofiliniu ganuliu, del kuriu didelio kiekio netaisyklingos formos branduolys daznai nematomas
Kur randami adipocitai?
Daugelyje organu, dideles lasteliu grupes vadinamks riebaliniu audiniu
Kokia yra adipocitu funkcija?
Specializuoti lipidų kaupimui citoplazmoje

Kur randami pericitai?
Prie kapiliaru ir pokapiliariniu venuliu

Kokia peritocitu funkcija?
Susitraukdami padeda teketi kraujui
Is kur kile makrofagocitai?
Is monocitu

Makrofagocitu funkcija
Fagocitoze

Nuo ko priklausomakrofagocitu forma ir dydis?
Aktyvumo
Is kur kile plazmocitai?
Is aktyvintu B limfocitu

Kokia plazmocitu funkcija?
Gamina imunoglobulinus
Koks yra plazmocitu gyvavimo laikas?
10-20 dienu
Kas yra plazmocitu branduolyje?
Heterochromatino gumbureliai

Kokie yra gemalo jungiamieji audiniai?
Mezenchima
Drebutinis jungiamasis audinys
Is kur kilusi mezenchima?
Mezodermos ir dalies ektodermos

Kokia mezenchimos funkcija?
Užpildo tarpus tarp gemalinių sluoksnių, ašinių organų,
įeina į placentos sudėtį
Kas sudaro mezenchima?
Mezenchimines lasteles + tarplasteline medziaga (pagr medz. ir kolageno skaidulos)

Kur randamas drebutinis jungiamasis audinys?
Vaisiaus virksteleje

Kokia yra drebutinio jungiamojo audinio funkcija?
Vaisiui judant neleidžia užspausti kraujagyslių
Kas sudaro drebutini jungiamaji audini?
Mukocitai ir tarplasteline medziaga

Kas yra visu suaugusiojo jungiamuju audiniu pirmtake?
Mezenchima
Ar kazkas veliau issivysto is drebutinio jungiamojo audinio?
Ne, jis pasalinamas su virkstele

Kas sudaro elastini jungiamaji audini?
Elastines skaidulos
Tarpus užpildo kolageno ir tinklinės skaidulos, fibroblastocitai ir fibrocitai
Pagr medziagos nedaug (del to nesimato baltu ertmiu nes jas uzpildo skaidulos)

Kur randamas elastinis jungiamasis audinys?
raiščiuose, stambių arterijų sienose (kur reikia atsparumo tempimo jėgoms)


Kas sudaro puruji kolagenini jungiamaji audini?
daug pagrindines medziagos
I, III tipo kolageno skaidulos, elastines skaidulos, isisdesto ivairiomis kryptimis
Vyrauja Fibroblastocitai (galima rasti ir putliuju, riebaliniu, makrofagocitu, plazmocitu lasteliu)

Kur randamas purusis kolageninis jungiamasis audinys?
Supa kraujagysles, limfagysles, sudaro tuščiavidurių organų pogleivį

Koks gali buti glaudus kolageninis jungiamsis audinys?
Taisyklingas
Netaisyklingas
priklauso nuo skaidulu issidestymo

Kas sudaro glauduji kolageninis jungiamaji audini?
pagr medz ir skirtingu lasteliu mazai
Fibrocitai
Būdinga daug, glaudžiai išsidėsčiusių skaidulų
Kur budingas glaudusis kolageninis jungiamasis audinys?
sausgyslės, derma (kur reikia mechaninio atsparumo)

Is ko sudarytas tinklinis audinys?
Tinkliniu lasteliu (retikulocitu)
Pagr medz
Tinkliniu skaidulu (III tipo kolagenas)

Kur randamas tinklinis audinys?
imuniniuose ir kraujodaros organuose
(blužnis, limfmazgiai, kaulų čiulpai)
Kokia yra tinklinio audinio funkcija?
Sudaro tinklą ir palaiko besiformuojančias imunines ir kraujo ląsteles

Kokiu tipu yra riebalinis jungiamasis audinys?
baltasis riebalinis a
Rudasis riebalinis a

Kokios yra Rudojo riebalinio audinio lasteles?
Ląstelės nedidelės, daugiakampės, branduolys ovalus, dėstosi centre, citoplazmoje daug įvairaus dydžio lipidų lašelių (todėl vadinamos daugialašėmis), Ląstelėse daug mitochondrijų
Ar rudasis riebalinis audinys turi kraujagysliu?
Taip, gausiai vaskuliarizuotas ir inertvuotas oarasimpatines nervu sistemos
Kokia yra rudojo riebalinio audinio funkcija?
Silumos gamyba
Kas sudaro baltaji riebalini audini?
Vienalasiai adipocitai
Tinkliniu skaidulu tinklas

Kokios yra baltojo riebalinio audiniu lasteles?
Pavienės ląstelės sferiškos, suspaustos – daugiakampės; branduolys ir organelės periferijoje

Kokia yra baltojo riebalinio audinio funkcija?
Išskiria hormonus;
atlieka termoizoliacijos funkciją ir
sugeria delnus bei padus veikiančias spaudimo jėgas
Metaboliškai aktyvios – reaguoja į hormoninius ir nervinius signalus
Nuo ko priklauso baltojo riebalinio audinio pasiskirstymas kune?
Lyties
Genetiniu veiksniu
Aplinkos veiksniu
Pigmentinis audinys yra ………. audinio rusis
Puriojo jungiamojo

Kas pigmentiniu audiniui suteikia pigmento?
Melanocitai - netaisyklingos formos, nedidelės ląstelės, gaminančios rudą pigmentą melaniną
Kur randamas pigmentinis jungiamasis audinys?
Raineleje, gyslaineje, genitaliju odoje po brendimo
Is ko sudarytas kraujas?
Lasteliu
Tarpines medziagos - plazmos

Kokios yra kraujo lasteles?
eritrocitai
Leikocitai
Kraujo ploksteles nera lasteles, ju vadinti trombocitais negalim, jos yra citoplazmos atplaisos
I ka skirstomi leukocitai?
Granulocitai - neutrofilai, eozinofilai, bazofilai
Agranulocitai - monocitai, limfocitai